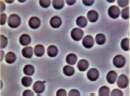

|
|
■包装資材
■包装機械
■物流機器
■測定機器 ■洗剤■ケミカル
■蛍光灯
■季節商品(夏)
■季節商品(冬)
■弱電工具
■ホイスト
■環境機器
■掃除機
■ムーブテック
■切削工具
■機械工具■調理厨房機器
■研究室用品
■安全防犯防災用品
■エクステリア
■新商品情報
■在庫処分情報
測定 MAIN PAGE
温湿度計-温度計 - 記録温湿度計-放射温度計 -重量はかり- 吊はかり- 電気測定器- 厚さ計-トルクゲージ-ノギス、マイクロメーター
騒音計-PH水質計-風速計-ガス臭気測定器-ニオイ臭気測定器-デジタル距離計-金属探知器-水分計 -照度計色計-枚数計数機器-回転計
プッシュプルゲージ-おんどとり-データロガー-シックネスゲージ-振動計 -電磁力計 -気象計器-光学機器-ファイバースコープ
電磁波・電位計-糖度計酸度計塩分計-屈折計濃度計-角度計-粉塵計-硬度計-圧力計流量計-健康管理-その他計測器-測定メインページ